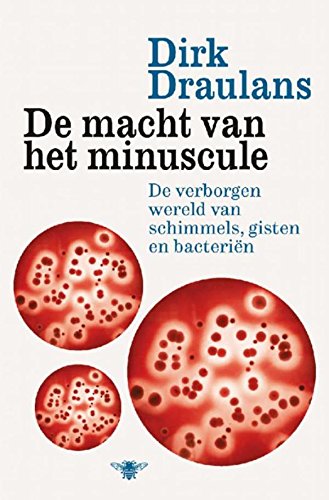

Dirk Draulans - Wetenschap Wiskunde Ebook

19 januari 2015 Lezen / Downloaden De macht van het minuscule Ebook (e Boek) Online PDF EPUB Kindle Nederlands Gratis 2017. Gratis Bienvenido a Mach TV Miami. El mejor canal para su Roku ... MiTV es el remplazo de MachTV, Quarks Pro o SpimeTV. MiTV es la solución que usted busca. Estable, altamente confiable, calidad de imagen y económico. Match.com Official Site Match.com is the number one destination for online dating with more dates, more relationships, more marriages than any other dating or personals site. Vine Official Site The entertainment network where videos and personalities get really big, really fast. Download Vine to watch videos, remixes and trends before they blow up. "Dann macht s bumm" Der Poldi Spot für die Türkei | W V "Dann macht s bumm" ... ist in der Online Redaktion für Agenturthemen zuständig. Bei W V schreibt er seit 15 Jahren über Werbeagenturen. Murda De Macht (prod. FS Green) Het komende jaar brengt de meest goedlachse rapper met een baard op elke eerste maandag van de maand via zijn website http www.murdaworld.com en # ... Machtv USA Home | Facebook Machtv USA. 5.1K likes. Bienvenidos a IPTV USA Miles de peliculas, series, conciertos y canales en vivo sin antenas ni cables. Los Mejores Estrenos Aquí!... e (wiskunde) Wikipedia Eigenschappen. Het getal is ook het grondtal voor de exponentiële functie ( macht) , ook geschreven als (). De natuurlijke logaritme is de inverse van de ... Bayerischer Volkshochschulverband e. V. bildungsklick.de ... Der Bayerische Volkshochschulverband e.V. erhielt den Zuschlag des ... Die auf bildungsklick.de zur Verfügung gestellten Inhalte dienen ausschließlich der ... Wie heeft de macht V.S. Deel 2 by Rikst Eringa on Prezi Opdrachten 22, 24 en 25. Jullie kunnen met het begrip Isolationisme uitleggen hoe de Amerikaanse presidenten omgingen met de buitenlandse politiek. Jullie kunnen twee ... Waarom is iets tot de macht 0 altijd 1? Startpagina ... Waarom is iets tot de macht 0 altijd 1? 4 jaar geleden gesteld via iPhone; Stel je hebt 26^0, waarom is dit dan 1 als 34^0 ook 1 is? 0 1 . 0 ....
Keine Macht den Drogen Gemeinnütziger Förderverein e.V ... Keine Macht den Drogen Gemeinnütziger Förderverein e.V., München. 3,772 likes · 39 talking about this · 30 were here. KEINE MACHT DEN DROGEN ist ein... NRW macht Schule e.V. NRW MACHT SCHULE EV Grundschulen unterstützen, Zukunft gestalten! Praktijk van de Macht Wat drijft mijn gesprekspartner?’ is voortaan de eerste vraag die ik mezelf stel. Medewerkers van project IJsei over de workshops van praktijk van de macht. M V aan de macht DenHaag.com Welke rol speelt gender in politieke campagnes en bij het uitoefenen van de macht? In het Politiek Café bij ProDemos wordt de de afgelopen ... De macht van filantropie (Blog V Wellens Isabelle) | Is ... Ik heb voor een bespreking rond de blog “Wat drijft filantropen” gekozen omdat deze enigszins aansluit bij de onderwerpen van mijn eigen blogs rond consumentisme ... De greep naar de macht standpunten van het V.N.V. ten ... Get this from a library! De greep naar de macht standpunten van het V.N.V. ten overstaan van vraagstukken van dezen tijd. [Frans Wildiers; Vlaams Nationaal Verbond.;] Macht eV Macht eV. Startseite; Men ... MachTv Portal MachTv Portal.
Match Highlight Update Latest Clip Videos Soccer ... Revista De La Liga – 29 August 2017. 362. The Xtra – 29 August 2017. 281. La Liga Review – 29 August 2017. 238. Premier League Views all . ... Power by Match ... Pak de Macht! Een ODE Aan de Kloppers, de Buurt ers, de Flyeraars, de Plakkers, de Telefonisten, de Muzikanten, de Streetart ers, de Hulpdiensters, de Bezorgers, de ... Match UK Ireland Official Site Start online dating with Match. Sign up and get access to our free dating trials as well as singles night and events near you. Machtsverheffen Wikipedia Definitie. Voor het natuurlijke getal ≠ is de de macht van het grondtal , genoteerd als , gedefinieerd als het product van factoren . Uit deze definitie volgt ook dat Macht Los e.V. Startseite | Facebook Macht Los e.V. Gefällt 774 Mal. Streetwork Projekt im Leipziger Süden für junge Menschen bis 27 in schwierigen Lebenssituationen oder deren Cliquen, wenn... MatchStat Tennis Stats | Football Betting Tips | Soccer ... Tennis stats and football betting tips. Bet for free win cash prizes. The best place online for tennis predictions with a virtual football betting game. Wissel van de macht | TVmaze Show Guide for Wissel van de macht. Includes an episode list, cast and character list, character guides, gallery, and more. MachTV Live Stream live IPTV with Nitro TV, WowTV and Pix TV MachTV Live offers 200+ Channels of Live Streaming IPTV and VOD movies in Spanish and English. TAAI gesprek over de macht v d (vastgoed)markt in Utrecht ... TAAI Samen stad maken het spel en het speelveld. Vraag je je af hoe initiatieven van de grond komen (en hoe niet)? Wie daarin een rol spelen? Ben je nieuwsgierig ... MachTV Roku IPTV now is QuarksPro Movies, Series, Sports ... MachTV Plus Roku ahora QuarksPro Distribuidores del canal mas demandado para Roku y Android Freight Forwarding and Global Logistics Service| Mach 1 ... Mach 1 Global is the go to logistics and shipping service for freight shipping, transport management, and other integrated logistic services in the nation. De macht van de President in de V.S. by Felix Mooij on Prezi Machtsverdeling in de V.S Is de macht van de president toe of afgenomen sinds het ontstaan van de V.S.? Amerikaanse politieke systeem Toename macht federale overheid Downloaden Parasieten bij mens en dier Ebook Online PDF/EPUB Nederlands. Downloaden De macht van het minuscule door Dirk Draulans Ebook Online PDF/EPUB Nederlands. Wetenschap Wiskunde e Boek.
No comments:
Post a Comment